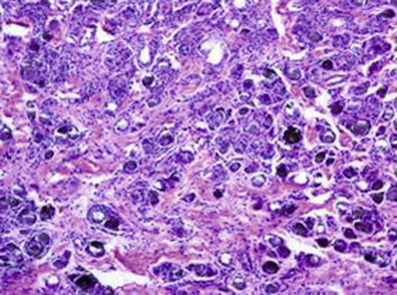
image

Immunofluorescence and related studies (Summarized in Table 7-10, Staining Characteristics of Subepidermal Blistering Diseases)
• Collagen IV immunostaining (stains the BMZ)
■ Performed on paraffin embedded sections to determine level of epidermal separation by comparing to stained BMZ
■ Is an alternative to salt-split skin immunofluorescence
■ Staining along floor of a blister: BP
■ Staining along roof of a blister: diseases targeting collagen VII (EBA and bullous SLE)
■ BE CAREFUL! Collagen IV immunostaining patterns are OPPOSITE of salt-split skin DIF (and IIF) patterns!
■ Performed on fresh frozen sections obtained from a biopsy of the patient’s affected/perilesional skin
○ Linear (Fig. 7-8)
♦ IgG and C3: bullous pemphigoid, lichen planus pemphigoides, EBA, cicatricial pemphigoid, anti-p200, anti-p105, and bullous SLE
➔ NEED further studies to distinguish!!!
♦ IgG, IgM, IgA, and/or C3 along BMZ = lupus band (Fig. 7-9)
♦ IgA in dermal papillae: DH (Fig. 7-10)
♦ IgG and C3 (“pemphigus pattern”): P. vulgaris, P. foliaceus, and paraneoplastic pemphigus
➔ Need further studies and clinical to differentiate
○ Linear to granular BMZ and intercellular: pemphigus erythematosus (Senear-Usher)
○ Linear BMZ and intercellular: paraneoplastic pemphigus
♦ Stippled, not thickened: LCV including IgA vasculitis and HSP
♦ Thickened and smooth: porphyrias with cutaneous involvement and pseudoporphyria; may also see linear BMZ staining in these entities!
• Salt-split skin studies (DIF/IIF): leads to a separation of the skin at the DEJ, and allows you to see where the immunoreactants are depositing; allows for distinction between various subepidermal blistering diseases (Table 7-10, Fig. 7-12)
■ n-serrated/u-serrated pattern evaluated on DIF and may be used as a substitute for salt-split skin analysis (Fig. 7-11)
• Indirect immunofluorescence (IIF): serologic study where blood is obtained from the patient and then tested for antibodies against skin antigens, using a normal/control sample of skin; staining patterns same as for DIF; generally less sensitive than DIF (Table 7-10)
Stay updated, free articles. Join our Telegram channel

Full access? Get Clinical Tree







